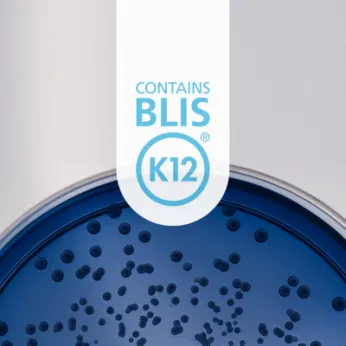

Blis Technologies Ltd
Information
Delivering proven health benefits through evidence-based, advanced probiotics
BLIS Technologies is an NZX-listed manufacturer of advanced probiotic strains that go beyond the gut.
Combining innovation with evidence-based research and the highest quality production controls enables the delivery of probiotic solutions for specific health targets including throat health, halitosis (bad breath), immune support, teeth and gum health and skin health. BLIS® products are sold throughout New Zealand and in Asia, Europe and the USA.
Ingredient Supplier: Specialty
Probiotics